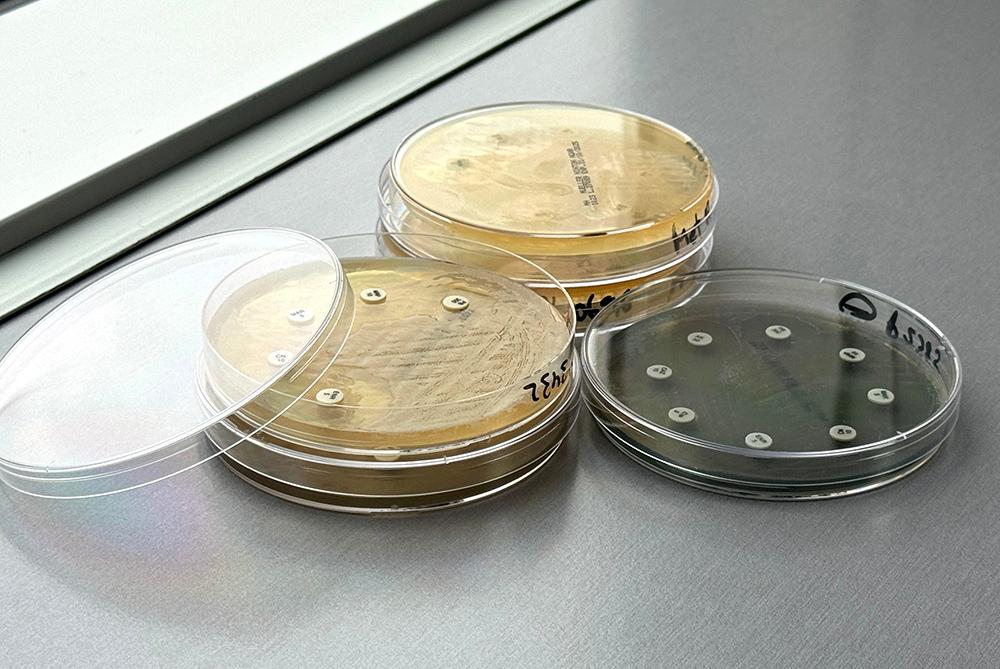

Incorporamos la clasificación AMEG - EMA en los antibiogramas de LETILAB: Aprende a cómo interpretar las categorías
Cultivos y antibiogramas de LETILAB
Como algunos ya sabréis, nuestros antibiogramas están especialmente dirigidos a procesos dermatológicos y tienen la particularidad de que seleccionamos los antibióticos en base al tipo de muestra que nos remitís y el tipo de microorganismo aislado. Gracias a ello, disponéis de diferentes opciones terapéuticas mejor orientadas a cada proceso y patología.
Para facilitaros la toma de decisiones cumpliendo con la normativa recientemente impuesta, desde inicios de septiembre ya podéis encontrar la letra correspondiente del grupo de clasificación AMEG al cual pertenece cada antibiótico testado en nuestros antibiogramas [D, C, B, A], de forma que os resulte mucho más sencillo seleccionar el tratamiento más adecuado en base a los resultados.
Ejemplo de un antibiograma de LETILAB
¿Por qué es importante esta incorporación?
Gracias a esta clasificación ahora incluida en el informe, os facilitará:
- Identificar rápidamente el nivel de prioridad y restricción del antibiótico.
- Tomar decisiones más informadas en la elección del tratamiento.
- Contribuir activamente a la reducción del riesgo de resistencias antimicrobianas.
- Cumplir con las recomendaciones de uso responsable establecidas por las autoridades y con ello la normativa actual.
Grupos de clasificación y cómo interpretarlos
La iniciativa responde a la necesidad de promover un uso más racional de los antimicrobianos, alineado con las recomendaciones de organismos internacionales como la Agencia Europea de Medicamentos (EMA) y la Organización Mundial de Sanidad Animal (WOAH), en el marco de la lucha contra la resistencia antimicrobiana.
¿Qué significa esta nueva letra?
En función del grupo al cual pertenezca cada antibiótico, su uso estará más o menos limitado cuando decidamos iniciar una terapia antibiótica, teniendo en cuenta los tratamientos disponibles en cada caso. Estas categorías son:
- D (Prudente): Antibióticos de menor riesgo para la salud pública. Son considerados de primera línea para uso veterinario, siempre que sea clínicamente apropiado.
- C (Precaución): Antibióticos que pueden utilizarse en veterinaria, pero con precaución cuando no haya alternativas de la categoría D, ya que existen alternativas en medicina humana.
- B (Restringir): Antibióticos de importancia crítica. Su uso debe limitarse a situaciones muy concretas que no permitan el uso de categorías C o D, y siempre bajo justificación clínica y pruebas de susceptibilidad antimicrobiana (antibiogramas).
- A (Evitar): Antibióticos de uso reservado exclusivamente para humanos. No deben utilizarse en medicina veterinaria salvo circunstancias excepcionales.
Clasificación de las clases de antibióticos para uso veterinario. Fuente: EMA
Recomendaciones generales
- Priorizar el uso de antisépticos siempre que sea posible, así como tratamiento antibiótico tópico frente al sistémico, tal y como se recomienda en las recientes Guidelines sobre piodermas caninas de la ISCAID. Visita el post sobre estas guías para más información.
- Evitar el uso innecesario, tratamientos prolongados o dosis insuficientes.
- Consultar siempre la clasificación antes de prescribir un tratamiento antibiótico.
Esta mejora implementada forma parte de nuestro compromiso con el uso prudente de los antibióticos y la mejora de la práctica clínica. Como profesionales dedicados al cuidado de una sola salud, debemos asumir la responsabilidad de mantener la eficacia de estos medicamentos esenciales para garantizar un futuro saludable para nuestros pacientes y la salud pública en general, a través de un uso correcto.
Si quieres revisar información más detallada puedes consultar el documento de referencia, y en caso de necesitar asesoramiento con los resultados de un antibiograma realizado en LETILAB puedes contactar con nuestro equipo técnico.
Juntos, avanzamos hacia un uso más responsable de los antimicrobianos.



